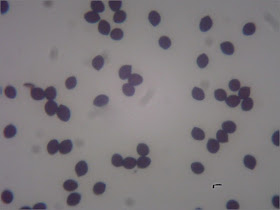

I saw some information on Twitter about
Multiclavula vernalis the other day and wondered if the wet heathy habitat at
Sussex Wildlife Trust's Graffham Common reserve might be a good place to look for it...
... So I went and had a good poke around in the wet bits yesterday. Didn't find any
M. vernalis.
I did find these though, some very small young fruit-bodies emerging from a lichen- and algae-covered bank.
The larger one at the top had a slightly striate cap...
... and beautiful decurrent gills.
I felt fairly certain this would be
Heath Navel Lichenomphalia umbellifera, which I recorded at Graffham Common in 2017 (
here), and thought I'd just take a quick look at the spores to confirm.
Now I'm confused.
This is what the spores (from a spore print) look like at 400x magnification, mounted in water.
 |
| Spores in water. 400x magnification. |
My measurements came out at 7.5-9.5 x 4.5-5.5 microns {based on 10 spores}; which is the right sort of ball park for
L. umbellifera.
But I looked at the spore images on Malcolm Storey's bio-images site (
here) and in his collections of
L. umbellifera the spores are hyaline with big oil droplets (like
this).
 |
| Spores in water. 1000x magnification. |
My collection doesn't have any conspicuous oil droplets. I'm wondering if I might have a different 'omphaloid' species here, such as
Omphalina pyxidata...? (Apologies about the darkness of the images, my microscope and angle-poise lamp are not cooperating today).
Moving on up the hill, I came across an old fire site.
I remembered that this was where I found an interesting-looking
Clitocybe specimen in 2017 which
– after much deliberation
– I ended up calling Clitocybe sinopica (read all about it here).
Looking closely, I saw this area was dotted with clusters of mushrooms with reddish-tan caps. Could this be my Clitocybe again?
Looking back at my notes from 2017, I saw that one of the features of C. sinopica which I was not able to detect then was a "strong mealy, farinaceous smell". I gave these fresh mushrooms a sniff and immediately recognised the mealy smell.
The fruitbodies produced a white spore-print, and masses of spores.
 |
| Spores in water. 400x magnification. |
My measurements came out at 7.8-9.1 x 4.4-5.8 microns {based on 10 spores}. Looking closely at the spores, they are mostly ellipsoid.
 |
| Spores in water. 1000x magnification. |
 |
| Spores in water. 1000x magnification (+ digital zoom). |
My collection seems to fit the description of
C. sinopica reasonably well (?), but would be nice to get it confirmed by someone who knows their
Clitocybes...
Finally, while I was photographing the
Clitocybe, I noticed some other mushrooms popping up across the fire site.
Some kind of
Inkcap, with a wooly ('tomentose') white base.
There were some younger specimens as well...
These showed distinctive fibrillose veil remnants covering the cap.
My best guess with these is
Bonfire Inkcap Coprinopsis jonesii (=
Coprinus lagopides), based on descriptions in Phillips and
here. The elliptical to subglobose shape of the spores would seem to support this. And I see Malcolm Storey recorded this speces down the road, at Lavington Common, in 2000 (
here)...
|
| Spores in water. 400x magnification. |
... But then I am never very confident identifying 'inkcaps'.
An interesting little haul, even if I am left a little uncertain on the identifications.
For the record
Date: 9 March 2019
Location: Graffham Common
Grid reference: SU9319